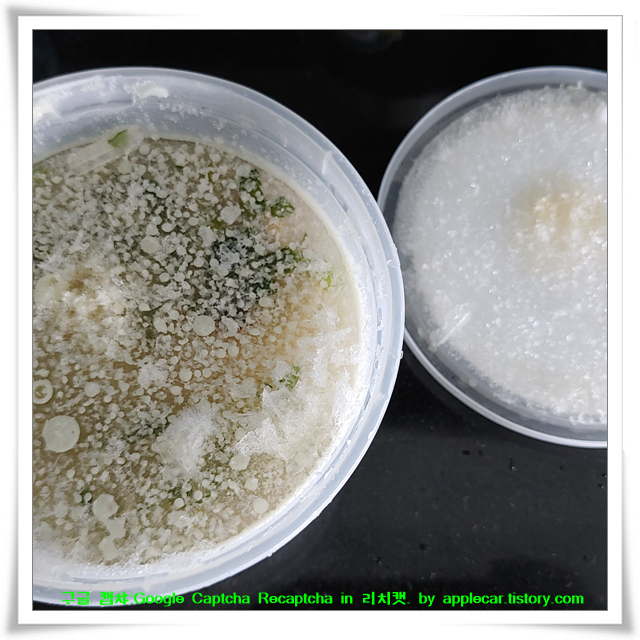

♠♠♠ 구글 캡챠, 리캡차 : 태국 간편식, 미스터도넛, ♠♠♠
구글 캡챠, 구글 리캡챠, 구글 캡차, 구글 리캡차, : Google Captcha, Google Recaptcha, Google Captcha, Google Recaptcha,
구글아....
이제 너가 맞춰봐~~~!!!
이제 너가 수십번, 수백번 클릭해 봐~~~!!!
이건 트럭 이니?
이건 자동차 니?
이게 자전거로 보이니?
이건 버스 니?
이건 택시 니?
이건 굴뚝 일까?
이건 교각 이니?
이건 계단 이니?
이건 보트 니?
이건 신호등 이니?
이건 야자수 니?
이건 오토바이 니?
이건 트랙터 니?
이건 횡단보도 니?
이건 언덕 이지?
이건 산 이지?
이건 산 또는 언덕 이니?
이게 소화전 인가?
이건 강아지 일까?
이건 고양이 일까?
이건 꽃 이니?
이건 악마니?
이건 천사니?
구글은 천사니?
구글은 악마니?
구글캡챠...너는 인간의 시간을 좀먹는 벌레야.
구글리캡차...너는 사람의 시간을 허비시키는 악귀야.
아직도 그런지를 모르지?
그래서 너는 악마가 되어가는 것이야.
이미 악마일수도 있고...
시간은 인간에게 가장 소중한거야.
그런데 너는 그걸 부정하는 영향력있는 악마야!!!
https://richcat.tistory.com/11906
만약 '데쓰노트' 라면....
카페 아마존에서 녹차마시면서... 리허설 감상중...ㅎㅎㅎ 데파시스트의 평범한 오후~~~^&^ 리허설 감상하면서... 무엇인가를 아이디어링 중인데... 저 아이디어링 노트가... 만약 '데쓰노트' 라면..
richcat.tistory.com

google....
now you guess
is this a truck?
is this a car
Does this look like a bike?
is this a bus
is this a taxi?
Is this a chimney?
Is this a pier?
Is this a staircase?
is this a boat
is this a traffic light?
is this a palm tree?
is this a motorcycle
is this a tractor?
Is this a crosswalk?
is this a hill?
is this a mountain?
Is this a mountain or a hill?
Is this a fire hydrant?
is this a puppy?
Could this be a cat?
is this a flower
is this the devil
is this an angel
Is Google an angel?
Is Google the Devil?
Google Captcha...You are a bug that eats human time.
Google Captcha...You are a demon that wastes people's time.
You still don't know?
So you are becoming a demon.
He could already be the devil...
Time is the most precious thing for humans.
But you are an influential demon that denies that!!!
구글 캡챠, 구글 리캡챠 : Google Captcha, Google Recaptcha. by applecar.tistory.com
Google Captcha- -애플카 티스토리
'■Google Captcha' 카테고리의 다른 글
| ♠♠♠ 구글 캡챠, 리캡차 : 센트럴페스티발 코코넛 먹기 ♠♠♠ (0) | 2022.03.25 |
|---|---|
| ♠♠♠ 구글 캡챠, 리캡차 : 파타야 마사지샵 가격, 파타야 인도인 골목, 파타야 항구 ♠♠♠ (0) | 2022.03.25 |
| ♠♠♠ 구글 캡챠, 리캡차 : 태국 문방구, 나이트바자, 파타야 야경, ♠♠♠ (0) | 2022.03.25 |
| ♠♠♠ 구글 캡챠, 리캡차 : 웡아맛 일몰, K-POP잡지, 태국 포르쉐 가격, 무개념 가미가제 ♠♠♠ (0) | 2022.03.25 |
| ♠♠♠ 구글 캡챠, 리캡차 : 태국 길거리에서 만난 새, 태국 영양제, 태국 건강음료 ♠♠♠ (0) | 2022.03.25 |